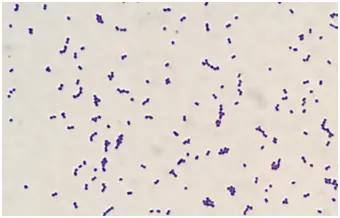
圖片描述

110年:醫學四(1)
25歲媽媽未規則產檢,急自然產娩出新生兒,患嬰出生後因呼吸窘迫進加護病房並做抽血檢查, 2 天後血液細菌培養有細菌滋生, Gram stain smear 如附圖所示,下列敘述何者正確?
A此圖細菌為革蘭氏陰性
B最常見的感染細菌為李斯特菌( Listeria monocytogenes )
C最有可能的感染途徑是經由母體產道上行性感染( ascending infection )導致
D此菌為新生兒泌尿道最常見之致病細菌
詳細解析
本題觀念:
新生兒早發型(early-onset)敗血症之病原體識別與感染途徑。此題探討出生後第2天出現血液細菌培養陽性,Gram stain 顯示紫色(Gram positive)鏈狀球菌,符合 Streptococcus agalactiae(Group B Streptococcus, GBS)的特徵,並以母體陰道上行性感染(ascending infection)為主要途徑。
影像分析:
Gram stain smear 中可見:
- 紫色(紫染)球菌,呈長鏈排列,大小約 0.5–1 µm。
- 無細胞壁破裂或內含芽孢之形態,排除 Bacillus 或 Clostridium 之可能。
- 以鏈狀排列(chains)為主要特徵,符合 Streptococcus 屬而非 Staphylococcus(呈叢狀)。
臨床意義:此 Gram positive cocci in chains 典型為 beta-hemolytic Streptococcus agalactiae(Group B strep),為 term 新生兒早發型敗血症最常見病原體。
選項分析
- 選項A 此圖細菌為革蘭氏陰性
錯誤。影像顯示紫色染色之球菌,屬革蘭氏陽性菌。Gram negative 球菌常見如 Neisseria 屬,呈雙
...(解析預覽)...
![醫師[2] - 細菌感染與免疫預防 - AI 圖文解析預覽](/_next/image?url=https%3A%2F%2Fbgvxfcrmbdvefjhuvrmt.supabase.co%2Fstorage%2Fv1%2Fobject%2Fpublic%2Fvisual-explanations%2F208%2F8494_t14fa2a36.webp&w=1920&q=75)
升級 VIP 解鎖圖文解析